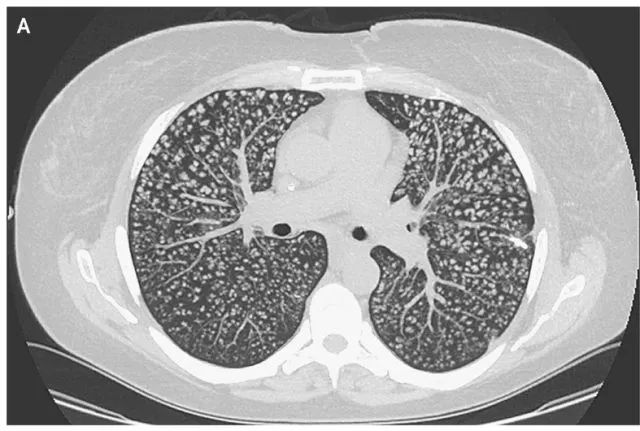
【病例】肺异物性肉芽肿1例CT影像表现

【病例】肺异物性肉芽肿1例CT影像表现
发布时间:2022-10-22
发布时间:2022-10-22
近日由来自美国亚特兰大艾墨立大学医学院的Dustin医生提供的案例,发布在新英格兰杂志上。
基本病史:女性,31岁,因行Roux-Y形胃旁路吻合术,长期接受全胃肠外营养,术后出现劳力性呼吸困难,并呈进行性加重1年。
临床检查:呼吸空气时血氧饱和度正常,无呼吸窘迫。双肺呼吸音正常,无喘息,无啰音。
影像学检查:胸部CT显示双侧肺部弥漫性多发性小叶中央型高密度结节(下图所示)。
图 A胸部CT显示双侧肺部弥漫性小叶中央型高密度结节
给出你的诊断吧?
病例结果

图 B 胸腔镜肺活检样本显示,组织细胞及富含嗜碱性物质的珊瑚状结构的异物巨细胞在血管外聚集。化学染色证实嗜碱性物质为交聚维酮(crospovidone),是许多口服药物的非活性成分
最终患者诊断为肺异物性肉芽肿
该疾病可注射或鼻吸入粉片之后发生的,通常是含有惰性填料如滑石粉、纤维素、交聚维酮的阿片类药物或兴奋剂。患者述自腹部手术之后一直使用血管通路进行全肠外营养以注射口服阿片类药物。
对于肉芽肿性肺疾病的诊断,一般来说临床表现和胸部的影像学表现均无明显的特征性表现,确诊多依赖于病理学的检查。当病理提示为肺肉芽肿病时,后续的诊断思路如下图。

图C 肉芽肿性肺疾病的临床诊断思路
治疗
肺异物肉芽肿目前尚无最佳治疗方法,该病例中处理阿片类药物的使用则是治疗的关键。随访6个月患者呼吸困难情况并未改善,但是日常工作并没有受到限制。
案例延伸
对于这种肺内多发的结节其解剖学分布,一般可分为1,支气管中心性分布;2,血管中心性分布;3,淋巴管性分布;4,随机分布。
上一篇:【病例】肺隔离症1例CT影像表现